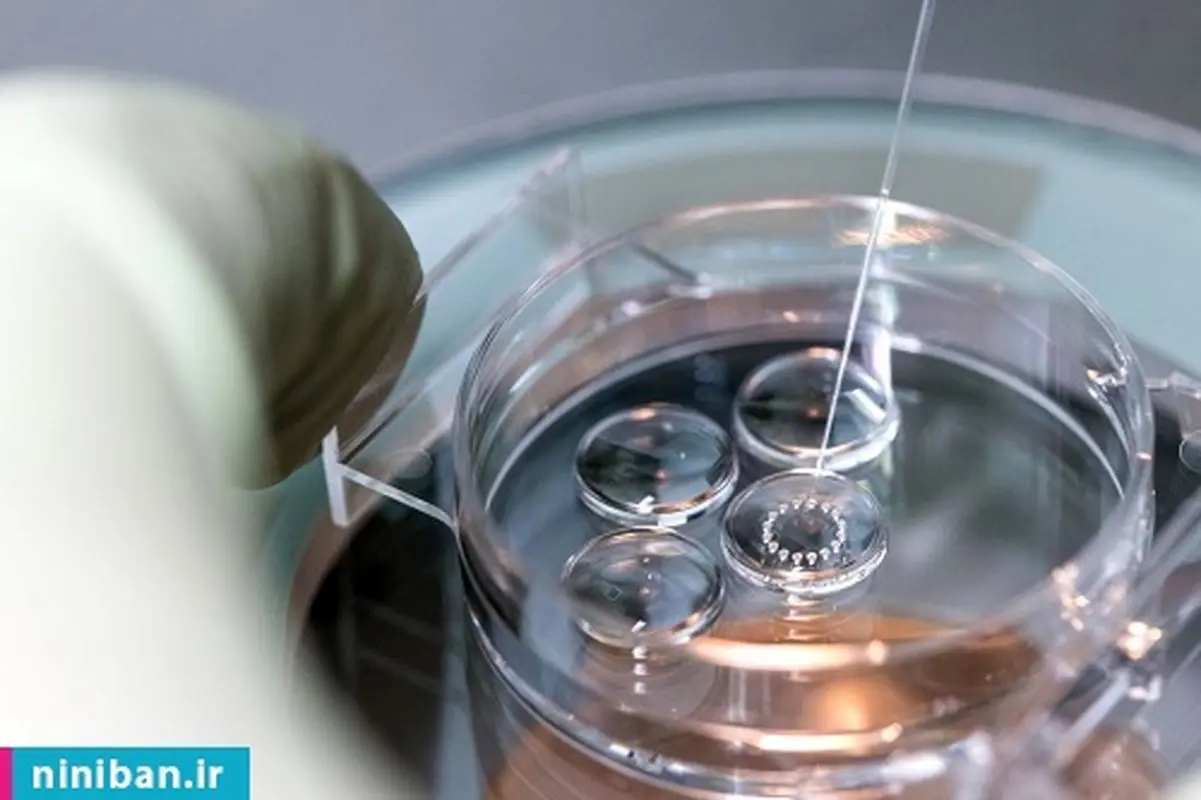

جنین شناسان متخصصانی هستند که با گامتها به نامهای اووسیت (تخمک) و اسپرم سر و کار دارند. آنها تخمها را با اسپرم بارور میکنند، کشت میدهند و تخمکهای بارور شده را تا مراحل مختلف رشد جنینی زیر نظر میگیرند. این مقاله را بخوانید تا با معروف ترین آزمایشگاه جنین شناسی در تهران آشنا شوید.

بیشتر بخوانید: انتقال جنین فریز شده، نکاتی که باید بدانید
در این مقاله میخوانید:
- معروف ترین آزمایشگاه جنین شناسی
- متخصصان جنین شناسی چکار میکنند؟
- چه اتفاقی در آزمایشگاههای جنین شناسی رخ میدهد؟
- متخصصان جنین شناسی چگونه از سلامت تمام تخمکها، جنینها و اسپرمها مطمئن میشوند؟
- چطور بهترین آزمایشگاه جنین شناسی را انتخاب کنیم؟
معروف ترین آزمایشگاه جنین شناسی
معروف ترین آزمایشگاه جنین شناسی عبارت است از:
آزمایشگاه پاتوبیولوژی و تشخیص مولکولی برسا
به کار گیرندهی دستگاههای تمام اتوماتیک، با ارائهی حداکثر کیفیت خدمات و انجام انواع تستهای تشخیصی و غربالگری سلامت جنین و نوزاد، معروف ترین آزمایشگاه جنین شناسی.
مرکز باروری و درمان ناباروری مام
پیشرفتهترین مرکز درمان ناباروری در خاورمیانه، دارای کلینیکهای ناباروری، اورولوژی، سلامت مادر و جنین و غیره، دارای معروف ترین آزمایشگاه جنین شناسی.

بیشتر بخوانید: تشخیص ناهنجاریهای جنین، با سونوگرافی ان تی
آزمایشگاه پاتوبیولوژی مرکزی
یکی از بزرگترین و مجهزترین آزمایشگاههای پزشکی کشور، ارائه دهندهی انواع غربالگریها و تستهای سلامت جنین، معروف ترین آزمایشگاه جنین شناسی.
آزمایشگاه تشخیص پزشکی شیلا
زیر نظر اساتید دانشگاه و متخصصین علوم، ارائه دهندهی آزمایشهای غربالگری مختلف و تعیین سلامت جنین در مدت نرمال بارداری، معروف ترین آزمایشگاه جنین شناسی.

بیشتر بخوانید: رشد مغز جنین، عواملی که در آن تاثیر دارد
متخصصان جنین شناسی چکار میکنند؟
متخصصان جنین شناسی با گامتها و تخمکهای بارور شده سر و کار دارند.
همانطور که گفتیم، متخصصان جنین شناسی با گامتها و تخمکهای بارور شده سر و کار دارند. آنها میتوانند بهترین جنین را برای انتقال انتخاب کنند و جنینهای باقیمانده را در دمای بسیار پایین در نیتروژن مایع برای استفادهی بعدی منجمد کنند.
همچنین اگر غربالگری ژنتیکی جنینها درخواست شود، متخصصان جنین شناسی آزمایشهای PGT-A و PGT-M را هماهنگ میکنند. وظیفهی انجماد و ذوب تخمکهای فریز شده و ارزیابی کیفیت آنها نیز برعهدهی جنین شناسان است.

بیشتر بخوانید: اکوکاردیوگرافی قلب جنین، چرا انجام میشود؟
چه اتفاقی در آزمایشگاههای جنین شناسی رخ میدهد؟
آزمایشگاه جنین شناسی مکانی است که در آن تمام تخمکها، اسپرمها و جنینها توسط گروهی از متخصصان بازیابی، لقاح و مراقبت میشوند.
آزمایشگاه جنین شناسی مکانی است که در آن تمام تخمکها، اسپرمها و جنینها توسط گروهی از متخصصان بازیابی، لقاح، کشت، تجزیه و تحلیل، نظارت، منجمد، ذوب و مراقبت میشوند.
در اینجا نمونههایی از روشهایی که در آزمایشگاه اتفاق میافتد آورده شده است. اکثر این روشها تنها در عرض ۵ تا ۷ روز انجام میشوند، زیرا این همان مدتی است که جنینها به مرحله بلاستوسیت میرسند و اکثراً در همین مرحله انتقال مییابند:
بیشتر بخوانید: بیانیه سازمان بهداشت جهانی درباره سقط جنین
- آنالیز مایع منی
- آنالیز تخمک
- تزریق داخل سیتوپلاسمی اسپرم (ICSI) که در آن یک اسپرم برای لقاح به تخمک تزریق میشود.
- نظارت بر جنین
- ارزیابی کیفیت جنین و پتانسیل لانه گزینی
- بیوپسی جنین برای آزمایش ژنتیکی
- هماهنگی آزمایشهای ژنتیکی جنین
- آمادهسازی جنین برای انتقال به رحم
- انجماد جنین، تخمک و اسپرم با استفاده از روش انجماد فوق سریع به نام انجماد شیشهای

بیشتر بخوانید: چند هفتگی دقیقاً قلب جنین تشکیل میشود؟
متخصصان جنین شناسی چگونه از سلامت تمام تخمکها، جنینها و اسپرمها مطمئن میشوند؟
کلید کیفیت و ایمنی این است که گام به گام رویههای عملیاتی استاندارد برای هر تکنیکی وجود داشته باشد. راستی آزمایی، شناسایی و رعایت دقیق همهی اصول برای ایجاد یک زنجیرهی ناگسستنی باروری حیاتی است.
در طول هر مرحله از فرآیند، کنترلهای کیفی، اقدامات حفاظتی و پروتکلهای دقیقی انجام میشود تا متخصصان اطمینان پیدا کنند که تمام نمونههای تخمک، جنین و اسپرم بهدرستی برچسبگذاری و ذخیره میشوند.

بیشتر بخوانید: علائم لانه گزینی جنین، موفق و کاذب
چطور بهترین آزمایشگاه جنین شناسی را انتخاب کنیم؟
چند ثانیه به این جمله فکر کنید: یک متخصص جنین شناسی اولین پرستار کودک شما است.
این جمله کاملاً درست است و هر چه بیشتر دربارهی آن فکر کنید، میبینید که چقدر انتخاب یک آزمایشگاه جنین شناسی خوب مهم و حیاتی است!
مواردی که در ادامه میخوانید، ویژگیهایی هستند که میتوانید آنها را هنگام انتخاب یک آزمایشگاه جنین شناسی در نظر بگیرید:

بیشتر بخوانید: روز جهانی سقط جنین ایمن، حق همه زنها
- دارای فناوری پیشرفته برای نگهداری، آنالیز و ذخیرهی جنینها
- تولید بهترین جنین ممکن به عنوان هدف آزمایشگاه برای بارداری موفق
- ایجاد محیطی بدون استرس و نزدیک به شرایط فیزیولوژیکی برای رشد جنین
- افزایش عمر جنین تا ۷ روز به کمک انکوباتورهای اکسیژن کم و محیط کشت مداوم (این کار به شما اجازه میدهد که بلاستوسیتهای بیشتری برای انتخاب داشته باشید.)
- آزمایش بلاستوسیتها با PGT-A برای رسیدن به نرخ لانه گزینی بالاتر در هنگام انتقال جنینهای طبیعی
- منجمد کردن دقیق بلاستوسیتها
- توانایی بالا در ذوب کردن جنین با نرخ بقای اغلب بیشتر از ۹۵درصد
- استفاده از پیشرفتهای مدرن در علم و فناوری برای رسیدن به نرخ لانه گزینی بیشتر
- فراهم کردن بهترین شرایط برای ایجاد جنینهای سالم طبیعی
- غربالگری جنینها برای اطمینان از انتقال بهترینها (این کار به افزایش احتمال لانه گزینی و بارداری موفق کمک میکند.)
- داشتن تیمی از جنین شناسان متعهد و بسیار آموزش دیده که برای به دست آوردن بهترین نتایج ممکن برای شما تلاش کنند.

بیشتر بخوانید: تشخیص بیماریهای جنین، با سونوگرافی آنومالی اسکن
بسیاری از شکستهای بارداری به دلیل ناهنجاریهای کروموزومی است.
در آخر باید گفت که بسیاری از شکستهای بارداری به دلیل ناهنجاریهای کروموزومی است. در واقع، وجود کروموزومهای بسیار زیاد یا خیلی کم (مثلاً سندرم داون که به عنوان تریزومی ۲۱ نیز شناخته میشود) در جنین میتواند شانس موفقیت در لانه گزینی را کاهش دهد. بنابراین، آزمایشگاههای خوب جنین شناسی باید بتوانند با تدابیری از بروز این مسائل جلوگیری کنند.
بیشتر بخوانید: جنین در چند هفتگی تکان میخورد؟
جمعبندی
این خیلی مهم است که شما معروف ترین آزمایشگاه جنین شناسی را بشناسید. زیرا اکثر آزمایشگاههای خوب و معروف، دارای یک تیم جنین شناسی مجرب هستند که از جدیدترین تکنیکها و فناوریها استفاده میکنند و باعث میشوند شما خیالتان جمع باشد!
برای اطلاعات بیشتر و آشنایی با بهترین آزمایشگاهها، به کلینیک نی نی بان سر بزنید.

برای ارسال نظر کلیک کنید
▼